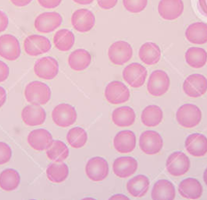

Human Normal Peripheral Blood Red Blood Cells (RBCs) / Mature Erythrocytes
Red blood cells (RBC), also called erythrocytes, are the most abundant cells in the blood. They are cells without a nucleus or mitochondria. The primary function of red blood cells is to transport oxygen (O2) and CO2 to and from various body tissues — via blood flow through the circulatory system. They are able to do this because they contain Hemoglobin. Additionally, erythrocytes are important in the maintenance of the acid-base balance within the body.
Our Normal PB Red Blood Cells / mature erythrocytes are collected from healthy donor peripheral blood by density gradient. All peripheral blood is collected in acid-citrate-dextrose formula A (ACDA) by leukapheresis from fully consented IRB approved donors that are tested negative for HIV, HBV, and HCV.